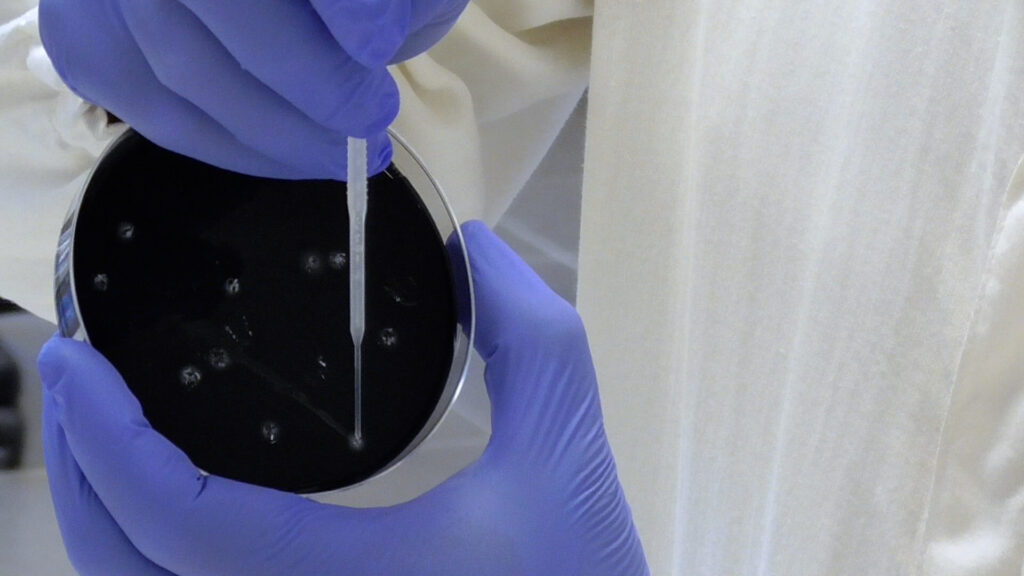

Identification of isolated colonies and ISO 7218
All horizontal methods for the search for pathogenic bacteria include, within the ISO standard, a paragraph related to the methods of identification / confirmation of presumed positive colonies. ISO 7218, one of the fundamental standards for the regulation of microbiological analyzes, indicates the operating procedures for the identification of colonies and includes molecular methods.
All PATHfinder Real-Time PCR kits proposed by Generon are based on international scientific literature, therefore they can be used for the identification of colonies within an ISO17025 accreditation scheme based on international standards.
| Target | |
|---|---|
| Alicyclobacillus acidocaldarius | Escherichia coli O:26 [wzx] |
| Alicyclobacillus acidoterrestris | Escherichia coli O:45 [wzx] |
| Alicyclobacillus spp. | Escherichia coli fattori di virulenza (stx1, stx2, eae) |
| Bacillus cereus e fattori di virulenza | Legionella pneumophila |
| Campylobacter termotolleranti | Legionella pneumophila Sierogruppo 1 |
| Clostridium botulinum | Legionella spp. |
| Clostridium botulinum A, B, E, F | Listeria monocytogenes |
| Clostridium Perfringens | Listeria spp. |
| Cronobacter spp. | Pseudomonas Aeruginosa |
| Enterobacteriaceae | Salmonella spp. |
| Escherichia coli | Shigella spp. |
| Escherichia coli H:4 [fliC] | Staphylococcus aureus |
| Escherichia coli H:7 [fliC] | Vibrio cholerae |
| Escherichia coli O:103 [wzx] | Vibrio parahemolyticus e fattori di virulenza (tdh/trh) |
| Escherichia coli O:104 [wzx] | Vibrio vulnificus |
| Escherichia coli O:111 [wbdL] | Xanthomonas Campestris |
| Escherichia coli O:121 [wzx] | Yersinia Enterocolitica |
| Escherichia coli O:145 [ihp1] | Yersinia pseudotubercolosis |
| Escherichia coli O:157 [rfbE] |
Advantages: Compared to biochemical and serological methods, when usable, PCR has innumerable advantages both in terms of practicality and in terms of cost / time savings for the operator:

Subscribe to our thematic newsletters to receive insights, news and curiosities of our sector. For more information fill out the contact form!